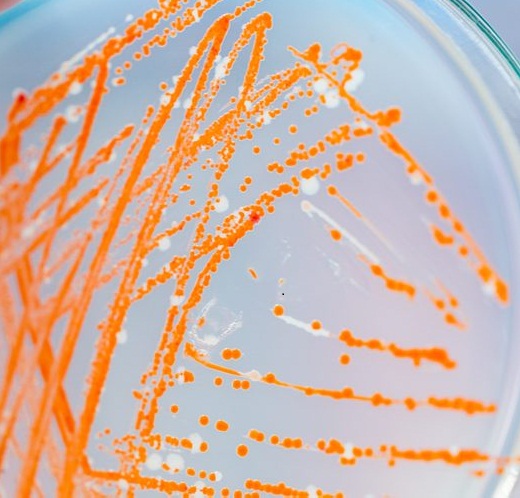
ODC-50

Sulfur has been recognized as an essential element for plant growth and considered
the fourth important nutrient element after N, P, and K. Sulfur deciency has increasingly
reported in Brassica, Alfalfa and canola. More than 95% of soil Sulfur is organic bonded. Although not readily plant available,
organic Sulfur compounds contribute to the Sulfur supply to plants via mineralization. Sulfur is a component of the amino acids
cysteine and methionine thus essential for protein synthesiss. Plants contain a large variety of other organic sulfur compounds,
such as glutathione, sulfolipids and secondary sulfur compounds which play an important role in physiology and protection
against environmental stress and pests
Sulfur has been recognized as an essential element for plant growth and considered
the fourth important nutrient element after N, P, and K. Sulfur deciency has increasingly
reported in Brassica, Alfalfa and canola. More than 95% of soil Sulfur is organic bonded. Although not readily plant available,
organic Sulfur compounds contribute to the Sulfur supply to plants via mineralization. Sulfur is a component of the amino acids
cysteine and methionine thus essential for protein synthesiss. Plants contain a large variety of other organic sulfur compounds,
such as glutathione, sulfolipids and secondary sulfur compounds which play an important role in physiology and protection
against environmental stress and pests
Soil with high pH, acts as an impediment in making Sulfur available to the plants. Addition of elemental Sulfur varying from 200 kg to 500 kg and application of BIO-SULF at the recommended rate (3 ltr/ha) will facilitate availability of Sulfur to plants. In places where application of Gypsum is practiced for reclamation of the soil with high pH, BIOSULF will have added advantage in the process of reducing the PH/soil reclamation.
The benecial bacterium (BIO-SULF) is suspended in liquid carrier upto 1x109 bacterial cells / ml of the product.
| TALC BASED BIOFERTILIZER |
|---|
| SEED TREATMENT : Mix 200-250gm BIO-ZINC in 300 ml water containing 5% Jaggery/ Gur as adhesive to make slurry. Add the slurry to seed an acre of land and mix. Dry the treated seeds in shade and sow in eld as soon as possible. Dried seeds should not be stored for long. |
| SEED PELLETING : BIO-ZINC coated seeds are sprinkled with powdered neem cake or neem leaf powder mix with hands before sowing. Seeds can also be coated with 2-3% of calcium carbonate if soils are acidic in nature |
| SOIL APPLICATION :1kg BIO-ZINC in 50kg of organic manure. Spread this mixture evenly in 1 acre elds |
| SOIL BROADCASTING : Mix 1.5kg BIO-ZINC with 50kg of cow dung. Add water to make the mixture damp and cover it with a porous gunny bag. Mixing should be done in shade. After 12 hours broadcast the mixture over 1 acre [0.4 ha] |
| APPLICATION THROUGH IRRIGATION : |
| LIQUID BIOFERTILIZER |
|---|
| SEED TREATMENT : Mix 50-100ml BIO-ZINC in clean water containing 5% Jaggery/Gur/ CMC as adhesive. Add the solution to seeds of an acre of land and mix. Dry the treated seeds in shade and store in cool and dark place till use. Seeds should be sown as soon as possible. |
| SEED PELLETING : BIO-ZINC coated seeds are sprinkled with powdered neem cake or neem leaf powder and mix with hands before sowing. Seeds can also be coated with 2-3% of calcium carbonate if soils are acidic in nature |
| SOIL APPLICATION :Use 500ml BIO-ZINC dilute with 100 lit of water. Spread this emulsion evenly in the elds |
| SOIL BROADCASTING :Mix 500 ml BIO-ZINC with 50kg of cow dung. Add water to make the mixture damp and cover it with a porous gunny bag. Mixing should be done in shade. After 12 hours broadcast the mixture over 1 acre [0.4 ha] |
| CAN BE USED WITH DRIP IRRIGATION TOO. |
Cereals & Millets, Legumes & pulses, Oil seeds, Vegetables, Fiber Crops, Herbs & Spices, Fruit and orchards
packing : 100ml/ 500ml / 1000ml